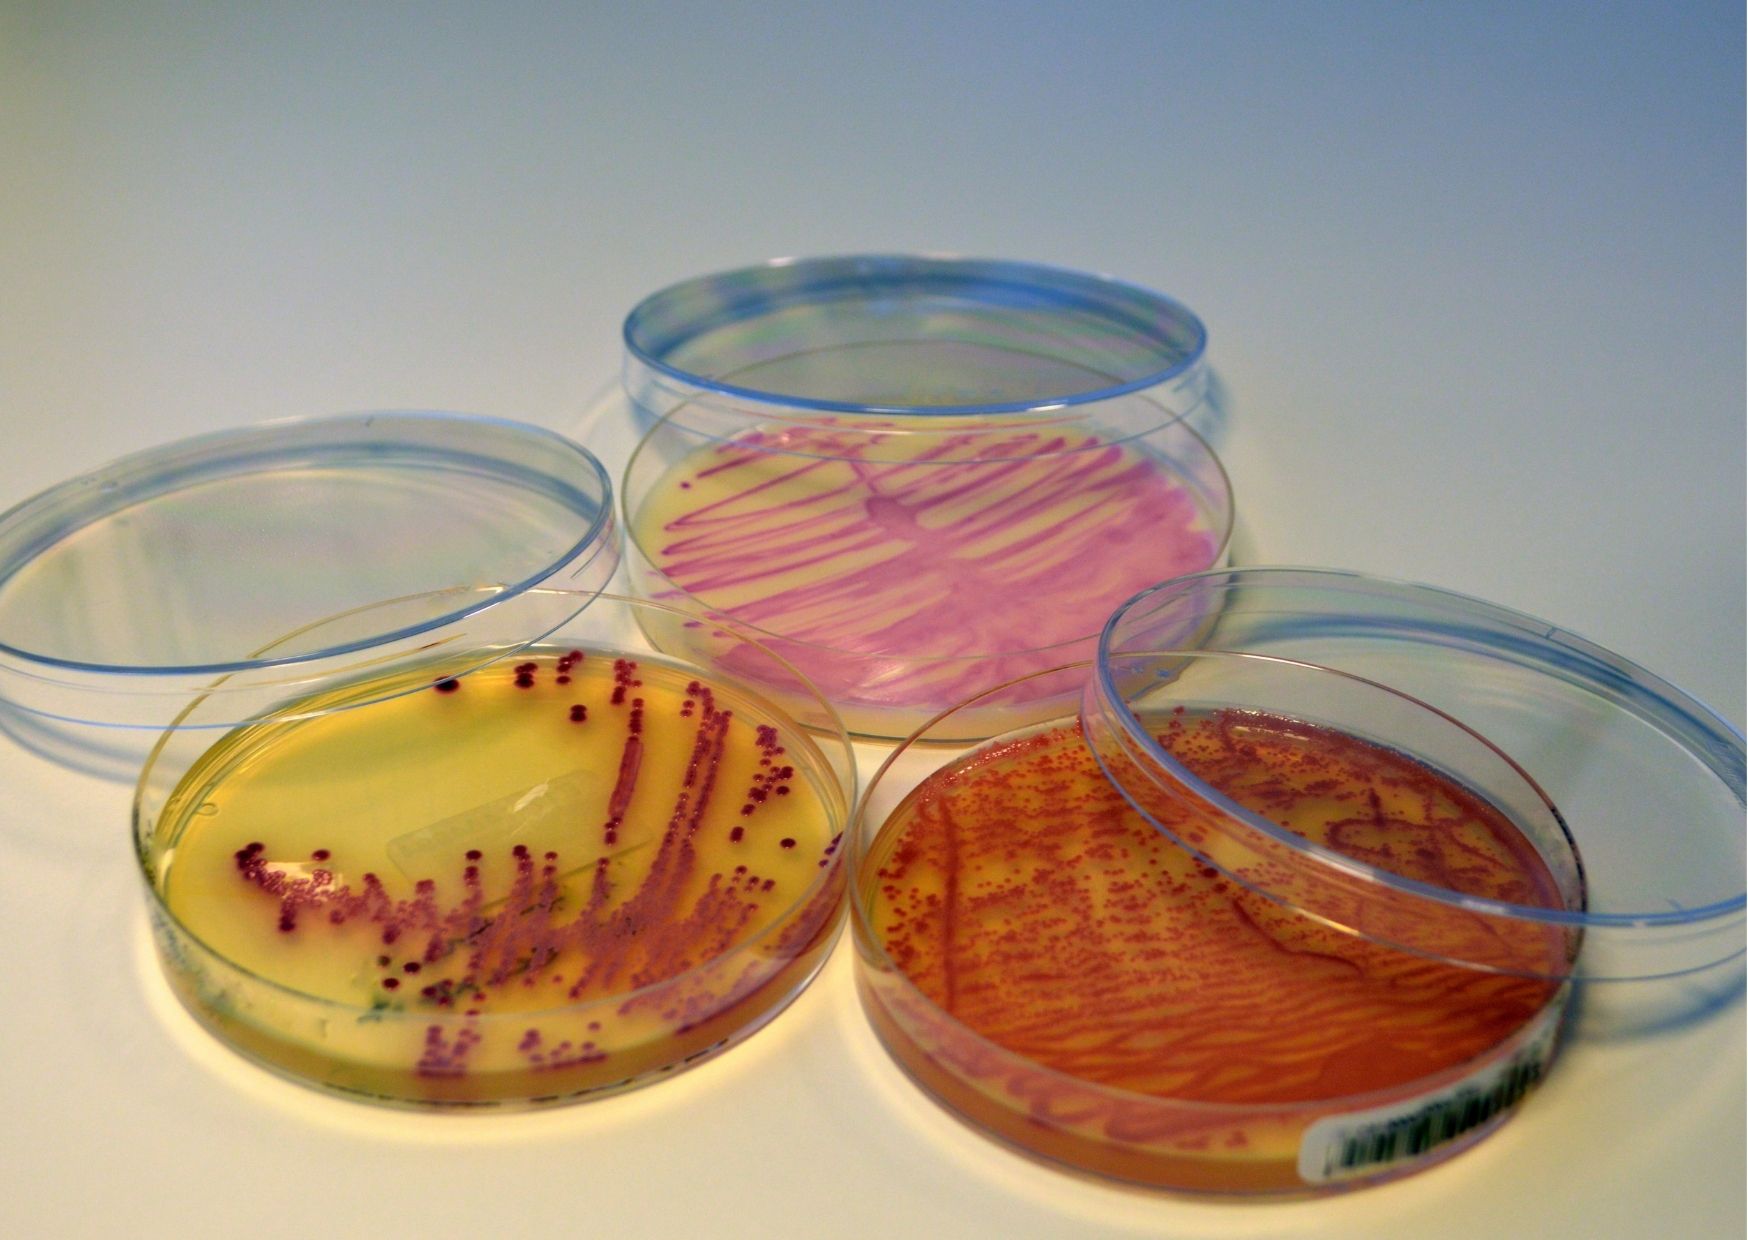
sepse

Pesquisadores desenvolvem sistema de identificação rápida da sepse
Um novo grupo desenvolveu uma técnica de identificação precoce da sepse: foi possível avaliar, com quase 100% de precisão, o início dos sintomas já nas primeiras duas horas de internamento.
[lwptoc colorScheme="inherit" borderColor="#f2f2f2"]
Sepse – o que é e como identificar
Para cada hora de atraso do manejo terapêutico adequado, há um aumento de 7,6% no risco de morte. Assim, um diagnóstico rápido e correto é essencial para o bom prognóstico do paciente.
Estamos falando da sepse, uma condição comum, que acomete cerca de 27 milhões de pessoas por ano, com risco de morte e muito heterogênea. O quadro decorre de uma resposta inflamatória sistêmica excessiva a uma infecção.
Os principais focos iniciais de infecção são pulmão, abdômen e trato urinário. São diversos os microrganismos causadores, mas a identificação do agente causador é bem-sucedida em apenas metade dos casos.
Bactérias gram negativas (E.coli, Klebsiella sp, Pseudomonas sp, Enterobacter sp, Proteus sp, Serratia sp, Neisseria meningitides), gram positivas (S.aureus, S.coagulase negativo, Enterococcus, S.pneumoniae) e anaeróbicas são as principais causadoras, ocorrendo em 40%, 30% e 10% dos casos, respectivamente. As demais internações são causadas por fungos (Candida spp, Cryptococcus sp), vírus (H1N1, vírus Epstein-Baar, Enterovírus, Vírus Sincicial Respiratório) e protozoários (Plasmodium sp, Entamoeba histolytica, Giardia lamblia, Trypanosoma cruzi), ou uma combinação de microrganismos.
Em condições normais, nosso sistema imune efetua uma resposta contra um patógeno de forma controlada e pontual. Quando um microrganismo é reconhecido em nosso organismo, células imunes e citocinas partem para o ataque, causando uma resposta inflamatória orquestrada.
Na sepse, por sua vez, esta resposta foge do controle. Por conta de fatores intrínsecos do paciente (imunossupressão, nutrição, idade, características genéticas) e do microrganismo (p.ex virulência), um processo inflamatório sistêmico se instala e a infecção se expande no organismo. O resultado é o comprometimento fisiológico e lesões múltiplas de órgãos.
A necessidade de intervenção imediata, associado com a dificuldade de identificação precoce, ajudam a tornar a sepse uma das maiores causas de morte no mundo. Os sinais inespecíficos da doença - incluindo febre, calafrios, taquicardia e hiperventilação - podem parecer à primeira vista ser de outras doenças. E, quando identificada, a variabilidade interindividual durante a sepse limita a triagem adequada dos pacientes.
Classificação em endótipos
O entendimento do papel da variabilidade individual na gravidade da doença levou a sepse a ser reformulada como uma síndrome composta por vários subgrupos denominados endótipos, que representam grupos distintos de pacientes biologicamente semelhantes associados ao desfecho e manifestação desta condição. Desta forma, os endótipos podem fornecer marcadores mais sensíveis, permitindo a previsão da gravidade da sepse, estratificação de risco e oportunidades para terapias individualizadas.
Entretanto, esta classificação ainda se mantém ineficaz e a identificação dos endótipos é confirmada após a confirmação da sepse, em geral quando os pacientes já requerem cuidados intensivos e antibióticos. Em partes, é como voltar à estaca zero.
Mas um novo estudo trouxe esperança aos profissionais da saúde e pacientes. Nas palavras dos pesquisadores:
"Se pudéssemos [..] identificar marcadores de gravidade e/ou status do endótipo nas primeiras horas de admissão na emergência, isso permitiria intervenções mais oportunas, agressivas e/ou imunomoduladoras para evitar a progressão para sepse mais grave, poupando antibióticos de amplo espectro, quando não necessários".
Máquinas são melhores que humanos
A pesquisa foi conduzida por um grupo da University of British Colombia. Os pesquisadores avaliaram os perfis de expressão gênica no sangue de 348 pacientes com sepse e 44 controles saudáveis. Os dados foram analisados usando aprendizado de máquina (deep learning) e mineração de dados para identificar assinaturas de genes clinicamente relevantes capazes de predizer a gravidade da doença, disfunção dos órgãos, mortalidade e endótipos/mecanismos específicos.

A pesquisa mostrou que a sepse grave pode ser detectada de forma precoce assim que o paciente chega pela primeira vez para atendimento médico. Comparativamente, leva de 24 a 48 horas, geralmente, para que médicos e profissionais de saúde possam ter certeza de que o paciente tem sepse. Com o emprego da técnica do estudo, a assinatura da expressão gênica pode ser avaliada tão cedo quanto 1,2 h após a admissão na emergência.
A técnica de deep learning foi capaz de identificar conjuntos de genes que predizem se um paciente irá adquirir sepse grave. Isso permitirá que os profissionais de saúde identifiquem rapidamente a resposta disfuncional do corpo a uma infecção, medindo esses biomarcadores associados à doença.
A técnica também tem 97% de precisão na classificação dos endótipos de sepse. Isso é importante porque dois subtipos identificados estão associados a um risco muito maior de sepse grave e morte. Além disso, a técnica também é útil na UTI, onde foi demonstrado que um endótipo era particularmente mortal, com uma taxa de mortalidade de 46%.
A identificação rápida do tipo de sepse ajudará os médicos a determinar o tratamento apropriado. A equipe também identificou outros biomarcadores que avaliam a gravidade da sepse (por exemplo, causando falência de órgãos) e o risco de morte.
Aplicações na rotina
Caso empregada na rotina, na primeira apresentação clínica, a identificação das assinaturas de expressão gênica que predizem a gravidade subsequente permitirá aos médicos identificar os grupos de pacientes de maior risco e permitir o uso adequado de antibióticos.
Outra vantagem é que muitos hospitais já contam com o equipamento necessário para a análise da expressão gênica no sangue dos pacientes. Desta forma, a implementação desta técnica seria facilmente realizada.
Além disso, algoritmos de deep learning são capazes de "aprender" conforme recebem dados. Isso possibilita a personalização da análise de acordo com os pacientes de cada hospital. Se a sepse é influenciada pela variabilidade biológica de cada paciente, é de se esperar que diferentes populações possam manifestar a doença de maneiras distintas.
Na eterna batalha de homens vs máquinas, este cenário parece ser vitorioso para nossos rivais sem sentimento (mas todos saem ganhando).
Referências:
Peter Meiszner, University of British Columbia. Machine learning and AI used to rapidly detect sepsis, cutting risk of death dramatically. Jan 11, 2022. MedicalXpress.
Arjun Baghela et al. Predicting sepsis severity at first clinical presentation: The role of endotypes and mechanistic signatures. eBioMedicine. Jan 2022.